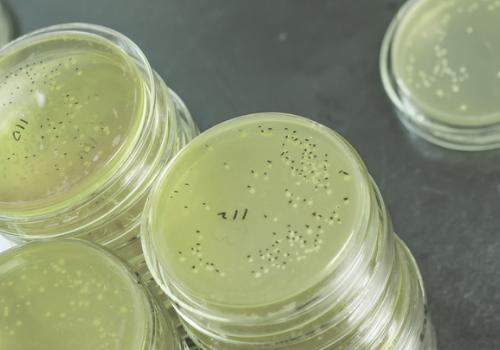

Solution Finder
Your guide to a productive environment
Use this search facility to find the content on our website that you need. You can define your profession, your industry or the issue you need to find a solution for, such as airborne dust, desiccation, ESD or excess heat.
Your issue
All
Adiabatic cooling
Desiccation
Dust
Indoor climate
Static electricity
Your Industry
All
Electronics
Food_Wine
Indoor climate
Museums_Theatres
Paint shop
Plastics and composites
Printing_Packaging
Wood
Identify yourself
All
Industrial manager or purchasing officer
Facility manager or process optimization specialist
HVAC and energy consultant
Project designer or consulting engineer
Supplier of equipment commodities or services